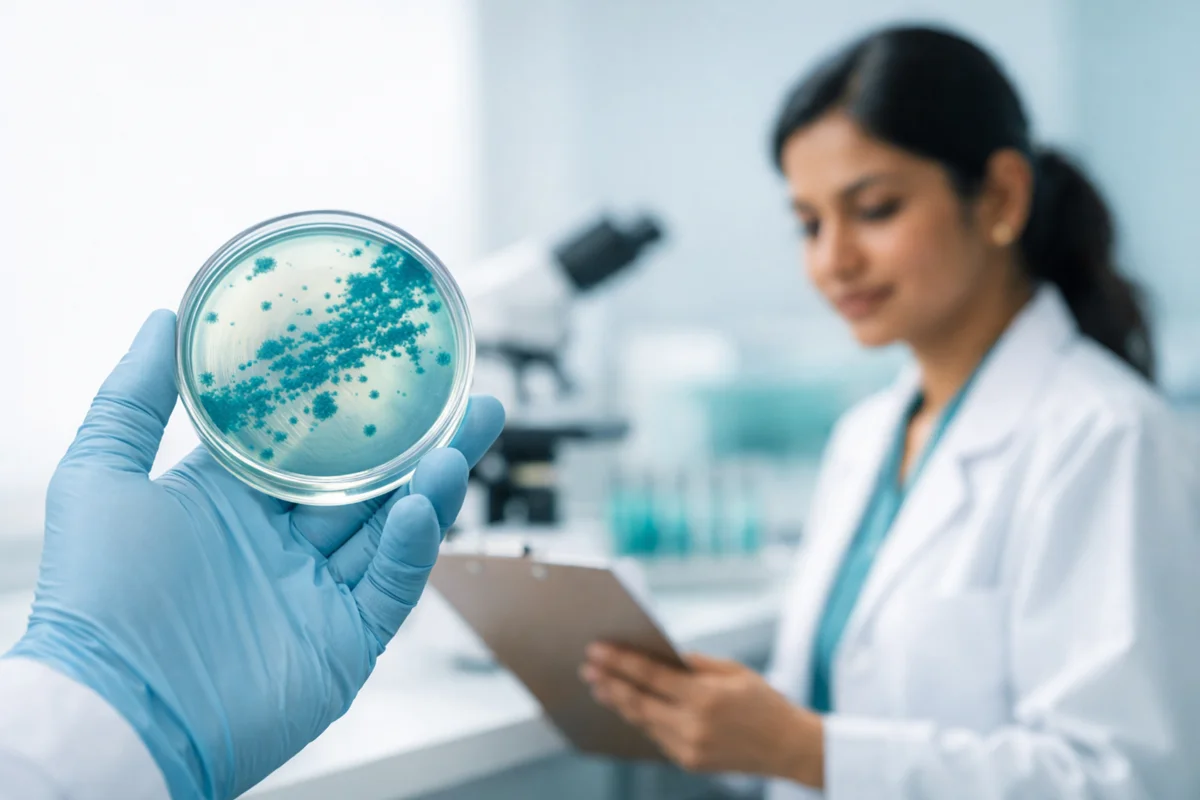
Pseudomonas aeruginosa bacteria

Preventive Healthcare
Anti-Obesity Day 2025: How To Prevent And Manage Obesity Through Healthy Living
Table of Contents
What Is Anti-Obesity Day?
Anti-Obesity Day is an annual awareness campaign dedicated to highlighting the growing health crisis caused by obesity. It focuses on educating people about the causes, risks, and preventive measures associated with excess weight and lifestyle-related disorders.
Obesity is not merely a matter of appearance; it is a chronic metabolic disease that increases the risk of type 2 diabetes, hypertension, cardiovascular disease, fatty liver, osteoarthritis, and certain cancers, according to the World Health Organization (WHO). The day aims to empower individuals to make informed lifestyle changes and promote a culture of health awareness.
By encouraging balanced eating habits, physical fitness, and regular health checkups, Anti-Obesity Day plays a crucial role in reducing the burden of obesity-related illnesses globally.
When Is Anti-Obesity Day 2025?
Anti-Obesity Day 2025 will be observed on Wednesday, November 26, 2025. The date marks a global call to action for individuals, families, schools, and workplaces to reassess their lifestyle habits and make healthier choices.
Every year, this observance brings together healthcare professionals, nutritionists, fitness experts, and policymakers to discuss strategies to prevent obesity and promote overall wellness. It also serves as a reminder that maintaining a healthy weight is a continuous journey, not a one-time goal.
The initiative encourages everyone to adopt sustainable habits—such as mindful eating, portion control, and regular physical activity—that contribute to long-term health and well-being.
Importance of Anti-Obesity Day
Obesity is one of the most pressing public health issues of our time. According to the World Health Organization (WHO), global obesity rates have nearly tripled since 1975. In India, approximately one in five adults is overweight or obese, according to the National Family Health Survey (NFHS-5, 2019–21). Anti-Obesity Day serves as a wake-up call to acknowledge this reality and take proactive measures.
The importance of this day lies in its multi-dimensional goals:
- Health Awareness: It helps people understand the medical risks of obesity and the long-term impact on the heart, liver, and metabolic health.
- Early Prevention: By promoting timely testing, routine monitoring, and healthy routines, individuals can avoid complications later in life.
- Destigmatisation: It shifts the narrative from body image to overall health, reducing social stigma and encouraging empathy for those struggling with weight management.
- Public Engagement: Governments, schools, and organisations are encouraged to conduct health drives, seminars, and fitness campaigns.
- Policy Advocacy: The day promotes policy-level initiatives like better food labelling, improved urban planning for walkability, and affordable access to healthy foods.
Ultimately, Anti-Obesity Day emphasises that obesity prevention is not just an individual responsibility but a shared social goal.
History of Anti-Obesity Day
Anti-Obesity Day was first launched in 2001 by the VLCC Group, a wellness and healthcare organisation based in India, with a vision to address obesity through education, early intervention, and awareness. The initiative soon gained recognition and spread across countries such as the UAE, Oman, and Bahrain, with healthcare professionals joining hands to expand its reach.
Over the years, the observance has evolved into a global platform advocating for preventive healthcare. The campaign initially started as a corporate wellness initiative but has now transformed into a community-driven movement encouraging people to make health a lifestyle priority.
Today, the day aligns with broader global health goals like the United Nations Sustainable Development Goal 3 (Good Health and Well-Being), making it a significant event in the global health calendar.
How to Participate in Anti-Obesity Day 2025
Taking part in Anti-Obesity Day doesn’t require major changes; small, consistent steps can make a meaningful difference. Everyone can participate in simple ways to promote healthier living within their families and communities.
Ways to get involved:
- Get a health checkup: Regular health tests, such as lipid profile, thyroid function, blood sugar, and BMI tracking, help identify potential risks early.
- Eat a balanced diet: Include fibre-rich fruits, vegetables, whole grains, legumes, and lean proteins while limiting processed, sugary, and high-fat foods.
- Move every day: Engage in physical activities like walking, swimming, dancing, or yoga for at least 30 minutes daily.
- Spread awareness: Use social media or community platforms to share facts about obesity prevention and inspire others to act.
- Host a wellness drive: Organise fitness sessions, nutrition talks, or weight-management challenges at workplaces or schools.
- Seek professional help: Consult dietitians, endocrinologists, or physiotherapists for personalised advice.
Conclusion
Anti-Obesity Day 2025 is a powerful reminder that the path to good health begins with awareness and preventive care. Obesity is manageable and preventable through small, consistent steps such as mindful eating, daily activity, and timely medical checkups.
At Metropolis Healthcare, we are committed to helping you take charge of your health with 4000+ diagnostic tests, comprehensive wellness packages, and specialised obesity panels. With home sample collection services from over 10,000+ touchpoints, fast turnaround times, and trusted accuracy, we ensure convenience meets care.
Book your health test today through our website, app, WhatsApp, or call, and take your first step toward a healthier, more active future — because prevention begins with awareness.
FAQs
When is Anti-Obesity Day observed?
Anti-Obesity Day is observed every year on 26th November. It serves as a global reminder to prioritise healthy living and manage weight effectively.
What are the main causes of obesity?
Obesity can result from a mix of poor dietary choices, lack of physical activity, genetic factors, hormonal imbalances, and psychological stress. Modern sedentary lifestyles and processed food consumption further aggravate the condition.
How can obesity be prevented and managed?
A healthy, balanced diet combined with regular exercise, stress management, adequate sleep, and periodic medical testing can effectively prevent and manage obesity. Maintaining a consistent sleep schedule and avoiding smoking or alcohol abuse also helps improve metabolism.
Why is systemic change important in fighting obesity?
Addressing obesity requires a collective approach. Systemic changes such as public awareness campaigns, nutritional education, and urban planning that encourage physical activity can make it easier for individuals to sustain healthy habits.
References
- https://www.who.int/news-room/fact-sheets/detail/obesity-and-overweight
- https://www.mayoclinic.org/diseases-conditions/obesity/symptoms-causes/syc-20375742
- https://www.vlccwellness.com/India/promotion-page/aod-nov.php